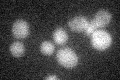
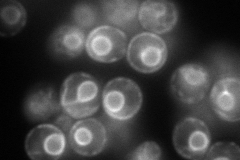
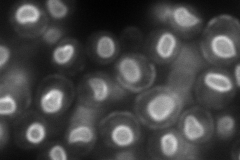
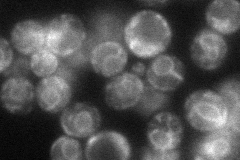

View description
Essential subunit of Sec63 complex (Sec63p, Sec62p, Sec66p and Sec72p); with Sec61 complex, Kar2p/BiP and Lhs1p forms a channel competent for SRP-dependent and post-translational SRP-independent protein targeting and import into the ER
Localization:
Intensity:
Fold change:
Significance:
-
C’ GFP library in SD
below threshold16.09 -
N' NOP1pr-GFP in SD
ER170.519 -
N' TEF2pr-mCherry in SD
cell periphery,nuclear periphery221.543 -
N' NATIVEpr-GFP in SD
ER65.7595 -
N' TEF2pr-VC and Cyto-VN in SD

below threshold23.7847 -
C’ GFP library in SD+DTT

cytosol13.560.84No -
C’ GFP library in SD+H2O2

cytosol14.80.91No -
C’ GFP library in Starvation Media

cytosol16.541.02No -
C’ GFP library on the background of Pup2-DaMP

below threshold -
C’ GFP library on the background of CCT mutant

below threshold15.54320.965293No
